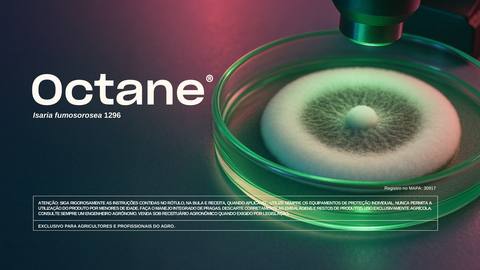

Localizador de soluções
A solução certa para a sua cultura
Tem dúvidas ou precisa de ajuda?
Encontrar um revendedorTem dúvidas ou precisa de ajuda?
Encontrar um revendedorNossa expertise
Notícias
-
 300 +soluções para produtores
300 +soluções para produtores -
 100 +países com distribuidores
100 +países com distribuidores -
 58 +anos de experiência
58 +anos de experiência -
 3000 +colaboradores em todo o mundo
3000 +colaboradores em todo o mundo